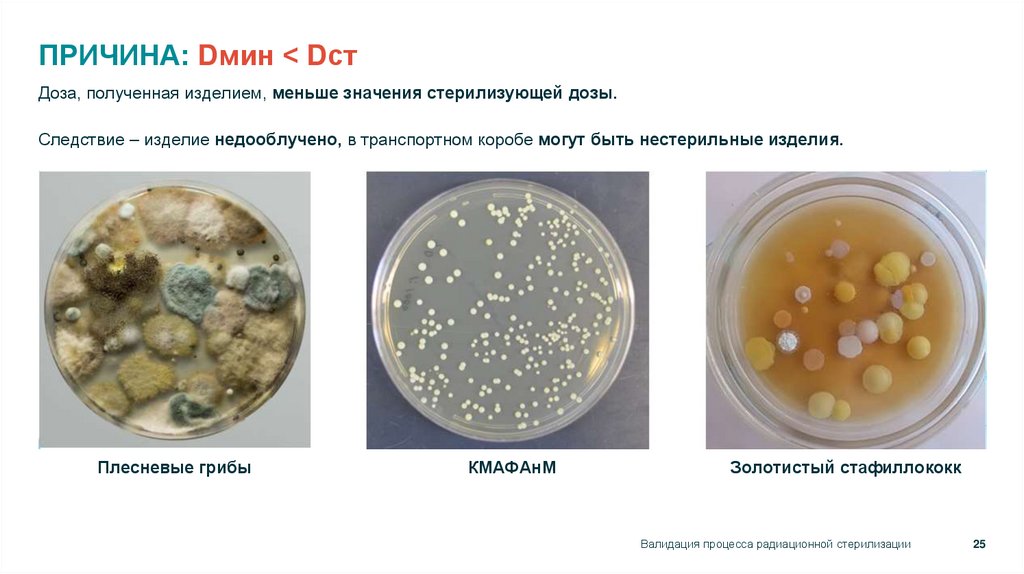
ПРИЧИНА: Dмин < Dст

Similar presentations:
dd931810-d3e3-4f29-bf0a-469ed47842a4
1. РАДИАЦИОННАЯ СТЕРИЛИЗАЦИЯ МЕДИЦИНСКИХ ИЗДЕЛИЙ
Май2023
Партнеры для роста
1
2.
Нашидоговоренности
Следуем времени
Участвуем в опросах
Когда все «зависло»
Пишем в чате
Выражаем эмоции
Подожди
Обнови страницу
Переподключись
Ведущий вернется
Радиационная стерилизация медицинских изделий
2
3. Стерильные и нестерильные медицинские изделия. Финишная стерилизация и асептическое производство
N 323-ФЗ "Об основах охраныздоровья граждан в Российской
Федерации" Статья 38. :
“1. Медицинскими изделиями
являются любые ….. изделия,
применяемые в медицинских
целях …..
2. Медицинские изделия
подразделяются на классы в
зависимости от потенциального
риска ….”
Медицинское изделие может быть стерильным или же нестерильным вне
зависимости от класса риска
Стерильные медицинские изделия могут быть получены при организации
асептического производства (ГОСТ Р ИСО 13408) или при финишной
стерилизации упакованного изделия.
Определение ГОСТ EN 556-1-2011:
4.1 Для того, чтобы медицинские изделия, прошедшие финишную
стерилизацию, могли быть отнесены к категории "СТЕРИЛЬНЫЕ",
необходимо, чтобы вероятность присутствия в (на) них
жизнеспособных микроорганизмов была менее или равна 1х10-6.
Радиационная стерилизация медицинских изделий
3
4. Методы стерилизации медицинских изделий
Промышленнаястерилизация
Внутрибольничная
стерилизация (ЦСО)
Радиационная стерилизация
(ускоритель или гамма-установка)
Низкая
температура
Газовая стерилизация
(оксид этилена)
Высокая
температура
Преимущества
промышленной
стерилизации изделий
однократного применения
перед внутрибольничной:
Надежность процесса
стерилизации
(валидацию процесса
стерилизации обеспечить проще
и дешевле)
Высокая производительность
(типовая производительность
площадки 60 м3 в год)
Низкая стоимость
(существенно ниже
операционные расходы)
Радиационная стерилизация медицинских изделий
4
5. Сравнение промышленных технологий стерилизации
ТермическаяХимическая
Паровая - обработка насыщенным
водяным паром под давлением.
Газовая – пары окиси этилена
(этиленоксидная стерилизация, (EtO)
ГОСТ Р ИСО 11134-2000
Промышленная стерилизация
влажным теплом
ГОСТ ISO 11135-2017
ЭТИЛЕНОКСИД
ГОСТ ISO 11137-1-2011
РАДИАЦИОННАЯ СТЕРИЛИЗАЦИЯ
низкая (малый объем)
высокая
высокая
средняя (часы)
длительная
(длительная аэрация)
низкая (минуты)
средняя (часы)
Экологическая безопасность
высокая
низкая
(токсичность и канцерогенность)
высокая
средняя
(утилизация Co-60)
Объем капиталовложений
низкий
средний
Операционные расходы
Высокие
Низкие
Требования к упаковке (цена)
термостойкая и паропроницаемая
упаковка
газопроницаемая упаковка
без ограничений
Совместимость с материалами
термостойкие материалы только
не абсорбирующие материалы
без ограничений**
Описание технологии
Регулирующий стандарт
Производительность
Длительность цикла обработки
Радиационная
Электронный
пучок ускорителя
(ebeam).
Гамма-излучение
от изотопа Co-60
(Gamma).
высокий
Низкие
Низкие
Радиационная стерилизация обладает наилучшими характеристиками, рост данной технологии
ограничивается высокими начальными капиталовложениями.
* требуется валидация процесса
радиационной стерилизации
** Источник данных для сравнения
- данные Акцентр 2023
Условные обозначения
Наилучший показатель по данному параметру среди рассматриваемых технологий
Средний показатель по данному параметру среди рассматриваемых технологий
Наихудший показатель по данному параметру среди рассматриваемых технологий
5
6. Распространение технологий стерилизации
В России большая доля стерилизацииэлектронным пучком в виду ряда фактов:
Источник: Данные Акцентр 2023
• Россия - лидер в ускорительной технике
• Высокая компетенция инженеров
• Низкая стоимость эл-энергии
Источник: МАГАТЭ 2023
Радиационная стерилизация преимущественно
предоставляется в виде out-source услуги.
Газовая стерилизация (оксид этилена)
используется на предприятиях, производящих
мед. изделия in-house.
Источник: данные IIA 2017
Радиационная стерилизация медицинских изделий
6
7. Природа ионизирующего излучения
Радиация - ионизирующееизлучение:
Радиоактивный распад
(естественный процесс)
Генератор излучения
(искусственный процесс)
поток микрочастиц, способных
ионизировать вещество (включая
отдельные случае видимого,
ультрафиолетового, рентгеновского и
гамма электромагнитных изучений, а
также потоки ускоренных частиц).
спонтанное изменение состава (заряда Z,
массового числа A) или внутреннего
строения нестабильных атомных ядер
путём испускания элементарных частиц,
гамма-квантов и/или ядерных фрагментов
Электротехнический прибор, в котором
генерируется на основе физических
законов поток ионизирующего излечения:
Ионизация
Виды распадов: Альфа-, Бетта-, Гамма-
УФ лампа
Электронно-лучевая трубка
Рентгеновская трубка
Ускоритель электронов
+
+
При распаде Co-60 вылетает
2 гамма-кванта 1,173 и 1,333 МэВ.
Радиационная стерилизация медицинских изделий
7
8. Промышленные установки для радиационной стерилизации
Пучок ускоренных электроновТормозное рентгеновское
излучение
Гамма-излучение
Излучение генерируется на
промышленных ускорителях электронов.
Излучение генерируется на промышленных
ускорителях электронов с последующим
преобразованием пучка электронов в
рентгеновское излучение при помощи
танталовой мишени.
Испускается радионуклидными
источниками (в основном используется
изотоп кобальт-60) в результате
радиактивного распада.
Плюсы:
высокая проникающая способность
высокая проникающая способность,
Минусы:
Минусы:
отсутствие радионуклидных источников
Проблемы с транспортировкой
низкая проникающая способность
излучения.
Минусы:
Проблемы с утилизацией отработанных
источников
Плюсы:
отсутствие радионуклидных источников
радиации
Высокая производительность и
эффективность
низкая эффективность и
производительность
Плюсы:
Радиационная стерилизация медицинских изделий
8
9. Радиационно–технологические установки для стерилизации
Ускоритель электроновГамма-установка
Излучение генерируется на
промышленных ускорителях электронов:
Излучение от радиоактивного распада
изотопа Кобальт-60:
Продукция обрабатывается в
коробках, непрерывно следующих друг
за другом.
Продукция обрабатывается в коробках
или паллетах;
При высокой плотности коробок
необходим переворот коробки
Продукция обрабатывается в режиме
партии или непрерывном режиме;
Длительность облучения 1-24 часа
Скорость обработки коробки 10-120
секунд.
Выживаемость микроорганизмов
строго зависит от поглощенной дозы доза D10 приводит к снижению
колониеобразующих единиц (КОЕ) на
порядок.
Не зависит от типа излучения
Основной контролируемый параметр:
Поглощённая до́за - Грей (гр, Gy) = Дж / кг
величина энергии ионизирующего
излучения, переданная веществу.
Выражается как отношение энергии
излучения, поглощенной в данном
объеме, к массе вещества в этом объёме.
Радиационная стерилизация медицинских изделий
9
10. Воздействие ионизирующего излучения на полимерные материалы
СшивкаДеградация
Прививка
Сшивкой полимеров называют физический
процесс, который модифицирует
внутреннюю молекулярную структуру
материала без изменения химического
состава вещества.
Деградация - реакция, протекающая с
разрывом связей основной молекулярной
цепи и приводящая к снижению
молекулярной массы полимера без
изменения химического состава.
Сшивка используется при
модифицировании полиолефиновой
(преимущественно полиэтиленовой и
поливинилхлоридной) изоляции кабелей и
проводов, изготовление упрочненных и
термоусаживающихся пленок, трубок,
производстве пенополиэтилена,
вулканизации эластомеров и изделий из
них (компонентов шин, каучуков с целью
изготовления на их основе термостойких
электроизоляционных лент и др.).
Разорванные связи, как правило,
окисляются
Прививка к основной цепи полимера
боковых ветвей, природа которых может
быть или близка к природе основной цепи
или сильно от нее отличаться. Свойства
привитых сополимеров в известной мере
определяются свойствами полимеров,
образующих основную цепь и боковые
ветви, но в то же время в привитых
сополимерах обнаруживаются свойства,
которыми ни один из образующих его
полимеров не обладает.
Радиационная стерилизация медицинских изделий
10
11. Радиационная стойкость полимеров медицинского назначения
МатериалДопустимый
уровень*
Комментарий
Термопласты
Акрилонитрил/бутадиен/стирол (АБС)
Ароматические полиэфиры (ПЭТ, ПЭТГ)
Бумага, картон, целлюлозные волокна
1000 кГр
1000 кГр
100-200 кГр
Защищено структурой бензольного кольца. Необходимо избегать высоких доз на ударопрочных материалах.
Очень стабилен, сохраняет прекрасную прозрачность. Рекомендуется для коннекторов Луер.
Фторполимеры
Тетрафторэтилен (ПТФЭ)
Полихлортрифторэтилен (ECTFE)
Поливинилиденфторид (ПВДФ)
Этилен-тетрафторэтилен (ЭТФЭ)
Фторированный этиленпропилен (ФЭП)
5 кГр
200 кГр
1000 кГр
1000 кГр
50 кГр
Выделяет газообразный фтор, распадается на порошок. Необходимо избегать использования.
Полиметилметакрилат
Полиакрилонитрил
Полиакрилат
Полицианоакрилат
100 кГр
100 кГр
100 кГр
200 кГр
Желтеют при 20-40 кГр; ясность частично восстанавливается при старении.
Желтеют при 20-40 кГр.
Желтеют при 20-40 кГр.
Адгезивы функционируют при 100 кГр с деградацией свойств менее 30%.
Полиамиды
PA-6, PA-66, PA-12
250 кГр
Обесцвечивается. Необходимо избегать тонких пленок и волокон. Необходима сушка перед формованием.
Поликарбонат
1000 кГр
Обесцвечивается, прозрачность восстанавливается при старении. Необходима сушка перед формованием.
Необходимо избегать использования.
Полиакрилы
*Уровень облучения, приводящий к незначительному изменению механических свойств
11
Радиационная стерилизация медицинских изделий
12. Радиационная стойкость полимеров медицинского назначения
МатериалПолистирол
Полиуретан
Поливинилхлорид (ПВХ)
Поливинилиденхлорид (ПВДХ)
Стирол/акрилонитрил (САН)
Допустимый
уровень*
Комментарий
10000 кГр
10000 кГр
100 кГр
100 кГр
1000 кГр
Все стиролы стабилизированы структурой бензольного кольца.
Отличная прозрачность и химическая стойкость к растрескиванию под напряжением. Сушка необходима.
Желтеет, можно тонировать для коррекции цвета.
Желтеет, выделяет HCl.
Желтеет при 40 кГр.
Полиэтилен
(LDPE, LLDPE, HDPE, UHMPE, UHMWPE)
1000 кГр
Сшивается: набирает прочность, теряет в удлинении.
Весь полиэтилен радиационно стабилен, низкая плотность наиболее устойчива.
Полипропилен
Гомополимер стабилизированный
Рандом, блок полипропилен
Гомополимер не стабилизированный
45-100 кГр
50-75 кГр
20 кГр
Подвержен охрупчиванию.
Более стабилен, чем гомополимер.
Необходимо избегать использования нестабилизированного полипропилена.
50 кГр
100-200 кГр
50 кГр
100 кГр
200 кГр
50-200 кГр
200 кГр
50-100 кГр
100 кГр
Избегайте многократной стерилизации.
Сшивается, слегка желтеет.
Избегайте многократной стерилизации.
Очень стабилен с системами отверждения серы или смолы.
Избегайте многократной стерилизации.
Избегайте многократной стерилизации.
Избегайте многократной стерилизации.
Плотность поперечных связей увеличивается больше в пероксидных системах, чем в платиновых.
Избегайте многократной стерилизации.
Полиолефины
Эластомеры
Бутилкаучук
Этилен-пропилен-диеновый каучук (EPDM)
Фторэластомер
Натуральный каучук (изопрен)
Бутадиен-нитрильный каучук
Полиакрил
Полихлоропрен (неопрен)
Силикон
Стирол-бутадиен-стирольные каучуки
*Уровень облучения, приводящий к незначительному изменению механических свойств
12
Радиационная стерилизация медицинских изделий
13. Марки СИБУРа, совместимые с радиационной стерилизацией
МаркаСтарое название
Примеры мед.изделий
ПЭНП:
10803-020
11503-070
15813-020
15803-020
ЛПЭНП:
PE LL30203 FH
PE5118QM
ПЭВП:
HD45552IM
HD85610IM
HD07580SB
ПЭ2НТ21-13
ПЭ2НТ22-12
ПЭ2НТ76-17
Банки, бутыли, флаконы.
Полипропилен:
PP R020BM/5
PP R481IM/5
PP R651IM/5
PP4240GM
PP4445S
PP4445T
Контейнеры для
биоматериалов, шприцы,
наконечники
Полиэтилентерефталат
ПЭТФ-Т
Плёнка для упаковки
мед.изделий,
колпачки для диализаторов
Бутыли, флаконы.
Вакуумные пробирки для взятия
крови, корпуса для
диализаторов
Max доза в изделии при
стерилизации, кГр
70
70
45
45
• Ведутся проекты по созданию радиационно-устойчивых: ПП рандом, ПП гомо
Радиационная стерилизация медицинских изделий
13
14. Для чего нужна валидация процесса стерилизации?
Для некоторых процессов, используемых впроизводстве, эффективность процесса не может
быть полностью проверена путем последующей
проверки и тестирования продукта.
Стерилизация является примером такого процесса,
так как невозможно проверить на стерильность
каждое изделие без ущерба для его назначения.
По этой причине процессы стерилизации
• проверяются для использования,
• регулярно контролируется производительность
процесса стерилизации
• и поддерживается оборудование
Проверки этапов стерилизации, как всех,
так и частично называются валидацией.
Валидация процесса радиационной стерилизации
14
15. Зависимость количества микроорганизмов от степени воздействия стерилизующего агента
Кинетика инактивации чистой культуры микроорганизмов физическимии/или химическими агентами, применяемыми для стерилизации
медицинских изделий, в общем случае точнее всего описывается
экспоненциальной зависимостью между количеством выживших
микроорганизмов и степенью воздействия стерилизующего агента.
Из этого неизбежно следует, что всегда существует некоторая
вероятность того, что микроорганизм может выжить, независимо от
степени примененного воздействия.
Следовательно, стерильность любого отдельного медицинского
изделия взятого из группы изделий, прошедших стерилизационную
обработку, не может быть гарантирована,
а стерильность обработанной группы выражается вероятностью
наличия жизнеспособных микроорганизмов на медицинском
изделии.
Валидация процесса радиационной стерилизации
15
16. Валидация процесса стерилизации
Валидация —документированное
подтверждение того,
что процесс стерилизации,
проводимый в пределах
установленных параметров
может осуществляться
эффективно
с воспроизводимыми
результатами
и приводит к получению
стерильного продукта
Валидация процесса радиационной
стерилизации необходима в следующих
случаях:
ISO 13485:2016 «Изделия медицинские.
Системы менеджмента качества.
Требования для целей регулирования»;
В рамках подготовки к регистрации
медицинского изделия в Росздравнадзоре
(Приказ от 19 января 2017 г. N 11н «Об
утверждении требований к содержанию
технической и эксплуатационной
документации производителя (изготовителя)
медицинского изделия»);
ГОСТ ISO 11137-1-2011 [ISO 111371:2006] «Стерилизация медицинской
продукции. Радиационная стерилизация.
Часть 1. Требования к разработке,
валидации и текущему контролю
процесса стерилизации медицинских
изделий»;
В рамках выполнения требований
стандарта ISO 13485 производителями
стерильных медицинских изделий, имеющих
сертифицированную систему менеджмента
качества - процессы стерилизации являются
одними из наиболее критических операций,
поэтому их необходимо валидировать;
ГОСТ Р 56431-2015 [GNTF/SG3/N9910:2004] «Система менеджмента
качества. Изделия медицинские.
Руководство по валидации процессов»;
Для демонстрации надзорным органам
того, что процесс стерилизации неизменно
выдаёт стерильный (т.е. безопасный)
продукт.
ГОСТ Р ИСО 14937-2012 «Стерилизация
медицинской продукции. Общие
требования к определению характеристик
стерилизующего агента и к разработке,
валидации и текущему контролю
процесса стерилизации медицинских
изделий».
Валидация процесса радиационной стерилизации
16
17. Порядок выполнения работ при валидации процесса стерилизации
Сбор входных данных:Определение выходных данных:
Определяются на основе исходной
информации:
• характеристики услуги, включая
функциональные и
эксплуатационные,
характеристики безопасности и
надёжности изделия;
• ТУ, международные и
национальные стандарты,
законодательные и другие
обязательные требования;
• Технологические возможности
стерилизующей организации,
требования к компетентности
разработчиков
• рекомендации по смене
упаковки, укладки продукции,
моделирование другой упаковки;
• информацию о методах и
средствах проверки;
• критерии приёмки.
Валидация процесса радиационной стерилизации
17
18.
1. Выбор метода определения стерилизующей дозы всоответствии с ГОСТ 11137-2-2011
2. Определение средней бионагрузки
3. Получение проверочной дозы
7. Определение максимальнодопустимой дозы
4. Проведение эксперимента с
проверочной дозой
8. Проведение эксперимента с
инкрементальными дозами
5. Интерпретация результатов
9. Интерпретация результатов
6. Установление стерилизующей дозы
10. Установление максимальнодопустимой дозы
11. Описание условий стерилизации, параметров контроля процесса
Валидация процесса радиационной стерилизации
18
19. Для определения стерилизующей дозы применяется один из двух подходов:
01При определении стерилизующей дозы необходимо обеспечить:
Получают данные по
количеству бионагрузки
и/или ее устойчивости к
радиации и используют
их для определения
стерилизующей дозы
Метод 1, Метод 2А, 2В
ГОСТ ISO 11137-2.
02
Стерилизующую дозу
выбирают из значений 25
или 15 кГр и
обосновывают выбор.
привлечение компетентной
микробиологической лаборатории
для проведения измерений
бионагрузки в соответствии с
ГОСТ ISO 11737-1 и испытаний
стерильности в соответствии с
ГОСТ ISO 11737-2
репрезентативность продукции
- ее соответствие той, которая
будет обрабатываться в
текущем процессе
соответствующий источник
радиации, способный
геометрически и
количественно точно
обеспечить требуемую дозу
Валидация процесса радиационной стерилизации
19
20. Метод 1 (п. 7 ГОСТ ISO 11137-2)
• Основан на экспериментально установленнойзависимости уровня бионагрузки от воздействующей
дозы.
• Выбирается минимум 10 изделий из одной партии
изделий, определяется средняя бионагрузка на
партии изделий.
• Отбирается 100 образцов изделий из данной партии
и облучается проверочной дозой, соответствующей
УС=1х10-2
• Уровень обеспечения стерильности продукции (УС) –
параметр, который определяет вероятность наличия
жизнеспособных микроорганизмов на отдельном
изделии. Предельное значение УС в РФ 1х10-6 .
Валидация процесса радиационной стерилизации
20
21. Почему проверочная доза?
• Прямой контроль стерильности затруднен, так какдля подтверждения УС=1х10-6 необходимо
протестировать на стерильность 1 млн изделий.
• Облучение проверочной дозой, соответствующей
УС=1х10-2 , дает возможность проверить на
стерильность не миллион, а сто изделий.
• Если получено не более двух положительных
результатов из 100 проведенных испытаний на
стерильность, для данного уровня бионагрузки
устанавливается стерилизующая доза.
Например: для уровня бионагрузки – 1 КОЕ/изд:
Дпров. = 3 кГр, Д стер.= 14,2 кГр.
Валидация процесса радиационной стерилизации
21
22. Установление максимально-допустимой дозы Dмакс.доп. (п. 8.1 ГОСТ ISO 11137-1)
Для установления максимальнойдопустимой дозы образцы облучают
тремя инкрементальными
(повышенными) дозами.
При определении максимально допустимой дозы необходимо обеспечить:
Для каждого виды изделия
рассчитываются свои
инкрементальные дозы.
После обработки максимально
допустимой дозой, продукция
должна соответствовать
установленным функциональным
требованиям на протяжении всего
определенного срока службы
(нетоксичность, апирогенность,
отсутствие раздражающего действия,
сохранение технических свойств).
привлечение учреждения,
способного произвести оценку
продукции с точки зрения ее
назначения
репрезентативность
продукции - ее соответствие
той, которая будет
обрабатываться в текущем
процессе
соответствующий источник
радиации, способный
геометрически и
количественно точно
обеспечить требуемую дозу
Валидация процесса радиационной стерилизации
22
23. Что происходит при неправильно выполненной валидации или при отсутствии валидации?
Валидация процесса радиационной стерилизации23
24. 1. Появление нестерильных медицинских изделий в стационарах
Основной риск нарушения качества процесса стерилизации – появление нестерильных медицинскихизделий, приводящих к развитию внутрибольничных инфекций при использовании.
Внутрибольничные инфекции являются колоссальной проблемой для системы здравоохранения.
1 Приведена неофициальная статистика. Официально в РФ ~1 ВБИ на 1000 пациентов. Проблема
некорректной статистики по ВБИ признана на уровне Минздрава и Роспотребнадзора. Приведена
оценка реального уровня ВБИ на основании расчетов НИИ Эпидемиологии Роспотребнадзора
24
25. ПРИЧИНА: Dмин < Dст
ПРИЧИНА: Dмин < DстДоза, полученная изделием, меньше значения стерилизующей дозы.
Следствие – изделие недооблучено, в транспортном коробе могут быть нестерильные изделия.
Плесневые грибы
КМАФАнМ
Золотистый стафиллококк
Валидация процесса радиационной стерилизации
25
26. 2. Несоответствие функциональных и эксплуатационных свойств изделия
Пожелтение продукции из марли, вздутие и разрыв индивидуальной упаковкиПожелтение и помутнение
полимерной продукции
Снижение значений по параметру
«разрывная нагрузка»
Рост «ложно-отрицательных» срабатываний тестсистем на основе ПЦР из-за снижения уровня pH
Выделение
формальдегида
Валидация процесса радиационной стерилизации
26
27. 2. Несоответствие функциональных и эксплуатационных свойств изделия
Пожелтение и деформацияизделия из ПЭТФ,
отсутствие герметичности
изделия («отсутствие
вакуума»)
Валидация процесса радиационной стерилизации
27
28. Снижение прочности нетканого материала «Спанбонд» при переоблучении
Облученный образец, доза 90 кГрВалидация процесса радиационной стерилизации
28
29. ПРИЧИНА: Dмакс > Dмакс.доп
ПРИЧИНА: Dмакс > Dмакс.допДоза, полученная изделием, больше значения
максимально-допустимой дозы.
Следствие – изделие переоблучено, в транспортном
коробе могут быть испорченные изделия,
непригодные для дальнейшего использования.
Для контроля максимально-допустимой дозы
облучения проводятся лабораторные испытания
облученных образцов:
• по санитарно-химическим показателям по ГОСТ Р
52770 (изменение величины рН вытяжки, УФпоглощение, формальдегид).
• на цитотоксичность, на раздражающее действие, на
гемолитические свойства по серии ГОСТ ISO 10993.
• на соответствие требованиям ТУ (внешний вид,
герметичность, разрывные нагрузки, сопротивление
отслаиванию липкого слоя).
Валидация процесса радиационной стерилизации
29
30. Реализация диапазона доз Dст — Dмакс.доп. на конкретной установке с ускорителем электронов
Одностороннееоблучение
Характеристика проникновения пучка: De –
доза на поверхности, составляет около
70%
Двустороннее облучение
Валидация процесса радиационной стерилизации
30
31. Установление диапазона доз в коробе
В образце размещаются дозиметры для построениякарты поля поглощенных доз, для последующего
анализа результатов.
Задача - найти места с наибольшей и наименьшей
поглощенной дозой в продукции.
Валидация процесса радиационной стерилизации
31
32. По результатам измерений:
1. Строится карта распределения дозы впродукции
2. Выбираются наиболее проблемные точки.
3. Выявляются причины возникновения
проблем
4. Ищется решение для исправления
проблемы
5. Производится повторная обработка с
полным исследованием продукции.
6. Выбирается контрольная точка на
поверхности коробки с минимальной
дозой
Валидация процесса радиационной стерилизации
32
33.
Определяется Кмин = Dмин / DктОпределяется Кмакс = Dмакс / Dкт
Определяется R = Dмакс / Dмин
Устанавливается режим облучения.
При рутинной стерилизации измеряется
только доза на поверхности короба, в
контрольной точке.
Должно соблюдаться условие:
Dмин =Dкт * Кмин,
Dмин ≥ Dст
Dмакс = Dкт * Кмакс, Dмакс < Dмакс.доп.
Диапазон доз в транспортном коробе
вычисляется с использованием
коэффициентов Кмин и Кмак.
Валидация процесса радиационной стерилизации
33
34. Прочие факторы, влияющие на стерильность продукции
Надлежащим образом валидированный, точно контролируемый процессстерилизации является не единственным фактором, влияющим на
надежность того, что продукция является стерильной, и в этом отношении
пригодна для предназначенного применения.
Необходимо обратить внимание на ряд других вопросов, среди которых:
микробиологическое состояние
входящего сырья и/или компонентов;
контроль оборудования и
процессов;
валидация и текущий контроль любой
используемой методики очистки и
дезинфекции;
контроль персонала и его гигиены;
способ и материалы, в которые
упаковывается продукция;
условия хранения продукции.
контроль окружающей среды, в
которой продукция производится,
собирается и упаковывается;
Валидация процесса радиационной стерилизации
34
35. Документы, которые оформляются при валидации процесса стерилизации
Инструкция по радиационнойстерилизации
Отчет по валидации процесса стерилизации
Инструкция по радиационной стерилизации выдается
на конкретное МИ.
Информацию о параметрах МИ (наименование, состав, назначение,
размеры, вес, укладка, и т.д.)
Форма установлена приказом Минздрава России от
22.05.2001 N 167.
Информацию о установленном диапазоне доз Dст – Dмакс.доп.
Информацию о реализации данного диапазона на конкретной РТУ
Информацию о валидации (квалификации РТУ)
Информацию режиме рутинной стерилизации (при ревалидации – за
межвалидационный период )
Информацию о квалификации сотрудников, проводящих стерилизацию
Информацию об основном и вспомогательном оборудовании
Информацию о контроле производства
Дату ревалидации
Оформляется на конкретную радиационную установку для каждого
вида изделий, различающихся укладкой в транспортную тару, весом,
габаритами и проч.
Технологический регламент процесса
радиационной стерилизации
Оформляется на конкретную радиационную установку
для каждого вида изделий, различающихся укладкой в
транспортную тару, весом, габаритами и проч.
Требования к содержанию регламентируются
Руководством Р 2.6.4/3.5.4-1040-01 «Общие требования
к технологическому регламенту радиационной
стерилизации изделий медицинского назначения»
Объединяет в себя:
Валидация процесса радиационной стерилизации
35
36. Постановление Правительства РФ от 27.12.2012 N 1416 «Правила государственной регистрации медицинских изделий» содержит список
документов, предоставляемых для регистрации МИкопия документа, подтверждающего полномочия
уполномоченного представителя производителя (изготовителя)
документы, подтверждающие результаты технических
испытаний медицинского изделия;
сведения о нормативной документации на медицинское изделие
техническая документация производителя (изготовителя) на
медицинское изделие
документы, подтверждающие результаты токсикологических
исследований медицинского изделия, использование которого
предполагает наличие контакта с организмом человека
документы, подтверждающие результаты испытаний
медицинского изделия в целях утверждения типа средств
измерений
опись документов
эксплуатационная документация производителя (изготовителя)
на медицинское изделие, в том числе инструкция по
применению или руководство по эксплуатации медицинского
изделия
фотографические изображения общего вида медицинского
изделия вместе с принадлежностями, необходимыми для
применения медицинского изделия по назначению (размером не
менее 18 х 24 сантиметра)
Валидация процесса радиационной стерилизации
36
37.
На каком этапе необходимо валидироватьпроцесс стерилизации?
Валидировать процесс стерилизации необходимо на финальной
стадии формирования технических условий перед проведением
испытаний для регистрации изделий.
В том числе валидации процесса упаковки и подтверждения срока
годности изделий.
Сколько времени потребуется на валидацию
процесса стерилизации?
В среднем выполнение всех работ занимает 3 - 4 месяца
Стоимость валидации процесса стерилизации?
Стоимость валидации процесса стерилизации зависит от количества
видов изделий, исполнений изделий и типоразмеров, количества
поставщиков материалов, в том числе материалов упаковки.
Валидация процесса радиационной стерилизации
37
38. Поддержание эффективности процесса
п. 12 ГОСТ ISO 11137-1Сохраняющаяся эффективность установленной
стерилизующей дозы должна быть показана путем
проведения:
a) определения бионагрузки с целью контроля
количества микроорганизмов, присутствующих на
продукции, в сравнении с заданным количеством
согласно техническим характеристикам;
b) аудита стерилизующей дозы с целью контроля
радиационной устойчивости бионагрузки на
продукцию.
п. 9.3.9 ГОСТ 8.651 и п. 4.1. РМГ-135
Периодичность проведения валидации - один год.
Валидация процесса радиационной стерилизации
38
39. Контакты
https://t.me/siburpolylab
Юлия Дорошко
Арсений Гусев
Татьяна Ермакова
Ольга Коваленко
Директор по
лабораторным сервисам
Технический
директор
Менеджер, Отраслевые
решения. Медицина
Менеджер
Акцентр
Акцентр
СИБУР
+7 926 078 27 45
+7 (901) 688 25 87
+7 (916) 329 88 01
+7 (916) 378 71 29
kovalenkoolv@sibur.ru
yuliya.doroshko@axenter.ru
ag@axenter.ru
ermakovats@sibur.ru
https://vk.com/
sibur_polylab
СИБУР Полилаб
39